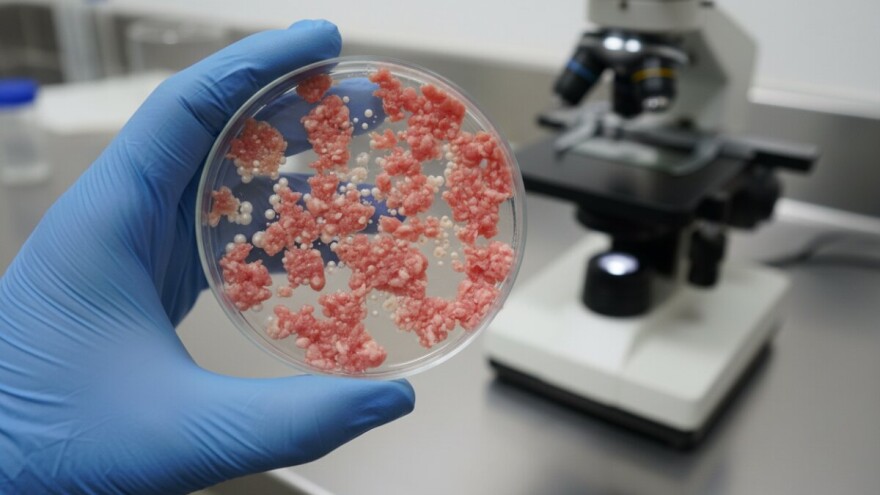
Salmonela opet trese Ledo!

Putem HR RASFF sustava zaprimljena je obavijest od Uprave za unaprjeđenje zdravlja Ministarstva zdravlja o nalazu bakterija iz roda Salmonella spp. u zamrznutom usitnjenom pilećem mesu (prisutnost u 25 g).
Mikrobiološkom analizom proizvoda utvrđeno je da isti ne udovoljava Uredbi (EZ) br. 2073/2005 Prilog I. Poglavlje 1. Kriteriji sigurnosti hrane, Točka 1.5., sukladno kojem se ne dozvoljava prisutnost bakterija iz roda Salmonella spp. u mljevenom mesu i mesnim pripravcima od mesa peradi stavljenima na tržište tijekom njihovog roka trajanja.
Zamjena proizvoda ili povrat novca
S tržišta se povlači Ledo Pileće meso usitnjeno od 500 grama, zamrznuti proizvod s datumom zamrzavanja 10. srpnja 2015. i rokom upotrebe do 9. srpnja 2016., jer je u mesu pronađena bakterija iz roda Salmonella.
Proizvođač je tvrtka Mesfino iz Čazme, a Ledo je distributer proizvoda. Iz Ministarstva napominju kako dostatna termička obrada hrane inaktivira uzročnika.
Ledo je također obavijestio potrošače o povlačenju navedenog proizvoda, te ih poziva da ih kontaktiraju ukoliko imaju navedeni proizvod kako bi im se omogućila zamjena za drugi ili povrat novca.
Foto: Ministarstvo poljoprivrede